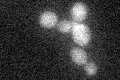
YJL057C
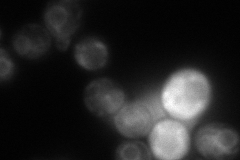
YJL057C
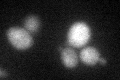
YJL057C

View description
Putative serine/threonine kinase; expression is induced during mild heat stress; deletion mutants are hypersensitive to copper sulphate and resistant to sorbate; interacts with an N-terminal fragment of Sst2p
Localization:
Intensity:
Fold change:
Significance:
-
C’ GFP library in SD
below threshold17.02 -
N' NOP1pr-GFP in SD

ER,vacuole63.0931 -
N' TEF2pr-mCherry in SD
ER85.8421 -
N' NATIVEpr-GFP in SD

below threshold23.0181 -
N' TEF2pr-VC and Cyto-VN in SD

#N/A0 -
C’ GFP library in SD+DTT
cytosol21.831.28No -
C’ GFP library in SD+H2O2

cytosol22.341.31No -
C’ GFP library in Starvation Media

cytosol17.671.03No -
C’ GFP library on the background of Pup2-DaMP

below threshold -
C’ GFP library on the background of CCT mutant

below threshold16.86160.990559No
